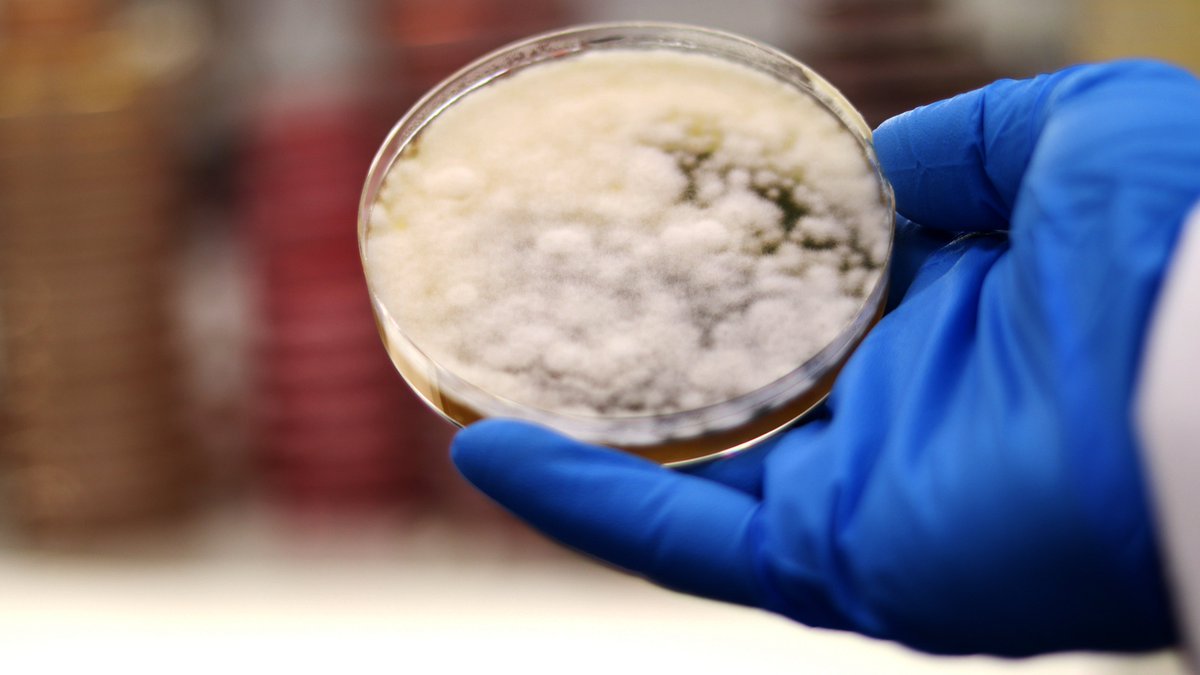
#CRISPR was used to modify the genes of Aspergillus oryzae (koji mold), creating a meat-like patty with boosted nutritional and sensory value by overexpressing genes for ergothioneine (an antioxidant) and heme (for color and flavor)
More <a href="/TheScientistLLC/">The Scientist</a>: shorturl.at/X0tul
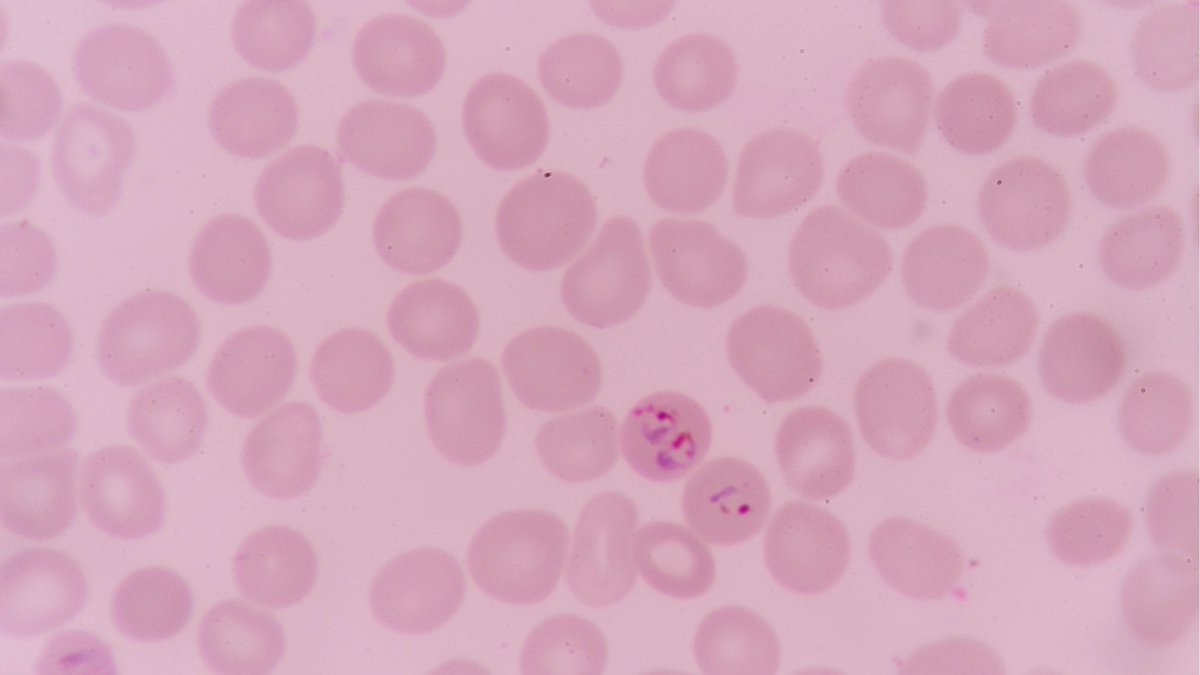
#CRISPRCas9 knockout screen used to identify metabolic host enzymes essential for the intracellular survival of Plasmodium and Theileria parasites, offering new opportunities for developing therapies.

More at <a href="/Nature/">nature</a>: shorturl.at/X617I

ERS Genomics
@ersgenomics
We enable access to the CRISPR/Cas9 intellectual property held by Nobel Prize-winner, Emmanuelle Charpentier. Talk to us about acquiring your license.
ID: 3226928939
https://www.ersgenomics.com/ 01-05-2015 20:43:53
738 Tweet
767 Takipçi
588 Takip Edilen


The convergence of biotechnology and culinary innovation is reshaping our food landscape. #Fungi have been used to create new flavors and textures through genetic modification. More SynBioBeta: shorturl.at/BLiSs


Researchers used a #CRISPR knockout screen to identify genes involved in spitting cobra venom cytotoxicity, revealing #heparin (a blood thinner) as a potential antidote. More Science Magazine: shorturl.at/fyF2W



#Casgevy from CRISPR Therapeutics (CRISPR Therapeutics) becomes the first therapy that uses CRISPR gene editing to be offered on the NHS for the treatment of beta thalassemia, eliminating the need for lifelong blood transfusions. Read more: bbc.co.uk/news/articles/…




Researchers used #CRISPR to enhance the adsorption capacity of carbon materials made from paper mulberry a fast-growing tree valued for its ecological, economic, and medicinal benefits. Read more at Horticulture Research: shorturl.at/WgcLI


#CRISPR is increasingly used in infectious disease research, helping to understand and potentially treat diseases such as HIV, SARS-CoV-2, and Chagas diseases. Read more at Technology Networks: shorturl.at/NSyMj




We are pleased to add Medicines Discovery Catapult (Medicines Discovery Catapult) to our family of licensees, providing access to CRISPR/Cas9 technology for a broad range of #drugdiscovery applications. Read more: shorturl.at/VrpFb


📢News: ERS Genomics & MDC partner to use #CRISPR technology, transforming medicine development. This boosts MDC’s capacity to create breakthrough products, reduce risks, increase productivity, and attract investment. Read more: hubs.li/Q02NzlGN0 #DrugDiscovery



#CRISPRCas9 has been used to enhance hybrid production in rapeseed, a major oilseed crop used in vegetable oil production. Read more Horticulture Research: shorturl.at/CcymR


The annual #Fierce50 report is out—congratulations to CRISPR Therapeutics for being named a 2024 honoree in the Breakthroughs category! This highlights the power of #CRISPRCas9, co-developed by Emmanuelle Charpentier, co-founder of CRISPR Therapeutics and ERS Genomics.



#CRISPR was used to modify the genes of Aspergillus oryzae (koji mold), creating a meat-like patty with boosted nutritional and sensory value by overexpressing genes for ergothioneine (an antioxidant) and heme (for color and flavor) More The Scientist: shorturl.at/X0tul

We’re excited to announce a #CRISPRCas9 license agreement with Université de Montréal, a leading Canadian research institution renowned for scientific innovation & tech transfer. Access to CRISPR/Cas9 enables the launch of two screening facility platforms: shorturl.at/Ru39b